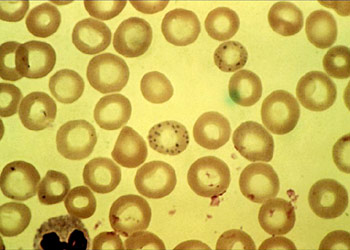

Verse of the Week 7 – The Clay
Season #5
زينب تقي
الطين مادة طبيعية تتكون من جزيئات صخرية دقيقة. عند خلطه بكمية كافية من الماء، يصبح قوامه طريًا ولزجًا. على عكس الطين العادي، يحتفظ الطين بشكله. يمكن تشكيله بالضغط عليه، أو دحرجته، أو تقطيعه، أو رصه في طبقات لتكوين أشكال متنوعة
يُعدّ الطين الرطب مادة بناء مفيدة جدًا لأنه يتصلب عند جفافه. يصبح الطين المحروق في الفرن شديد الصلابة، وقد يدوم لفترة طويلة جدًا. وقد عثر علماء الآثار على أوانٍ وأوعية مصنوعة من الطين يعود تاريخها إلى آلاف السنين
يُعدّ الطين الرطب مادة بناء مفيدة جدًا لأنه يتصلب عند جفافه. يصبح الطين المحروق في الفرن شديد الصلابة، وقد يدوم لفترة طويلة جدًا. وقد عثر علماء الآثار على أوانٍ وأوعية مصنوعة من الطين يعود تاريخها إلى آلاف السنين
Hussein Alkharsan
No other earth material has so wide an importance or such extended uses as do the clays. They are used in a wide variety of industries. As soils, they provide the environment for almost all plant growth and hence for nearly all life on the Earth's surface. They provide porosity, aeration, and water retention and are a reservoir of potassium oxide, calcium oxide, and even.
The use of clay in pottery making antedates recorded human history, and pottery remains provide a record of past civilizations. As building materials, bricks (baked and as adobe) have been used in construction since earliest time. Impure clays may be used to make bricks, tile, and the cruder types of pottery, while kaolin, or china clay, is required for the finer grades of ceramic materials. Another major use of kaolin is as paper coating and filler; it gives the paper a gloss and increases the opacity.
Refractory materials, including fire brick, chemical ware, and melting pots for glass, also make use of kaolin together with other materials that increase resistance to heat.
Certain clays known as fuller's earth have long been used in wool scouring. In rubber compounding, the addition of clay increases resistance to wear and helps eliminate molding troubles.
The use of clay in pottery making antedates recorded human history, and pottery remains provide a record of past civilizations. As building materials, bricks (baked and as adobe) have been used in construction since earliest time. Impure clays may be used to make bricks, tile, and the cruder types of pottery, while kaolin, or china clay, is required for the finer grades of ceramic materials. Another major use of kaolin is as paper coating and filler; it gives the paper a gloss and increases the opacity.
Refractory materials, including fire brick, chemical ware, and melting pots for glass, also make use of kaolin together with other materials that increase resistance to heat.
Certain clays known as fuller's earth have long been used in wool scouring. In rubber compounding, the addition of clay increases resistance to wear and helps eliminate molding troubles.
Narjes Ghaddar
Did you know that toilet is made out of Clay? Yes, Clay plays a big role in our everyday life because of its three main qualities: abundance, plasticity and durability. Clay last for a long time and tell us about the past civilisation. Like Ancient egypt who used it for their everyday Life from cooking to transporting goods. Till now its used for everything from making toilet, computer industry to Coffee mug. This is what to book: Clay: The History and Evolution of Humankind's Relationship with Earth's Most Primal Element by Suzanne Staubach explaions to us.
Glory to Allah to best of creators.
Glory to Allah to best of creators.
فاطمة فارس
البث الحي
تسجيل
القائمة المفتوحة
صحة
|
الولايات المتحدة الأميركية
دراسات تؤكد خلق الإنسان من طين
Normal Red Blood Cells
Published On 24/10/2003
24/10/2003
انقر هنا للمشاركة على وسائل التواصل الاجتماعي
شارِكْ
undefined
أثبتت دراسات وبحوث جديدة أن مواد موجودة في الطين لها دور رئيسي في بعض العمليات الأولية لتكوين الحياة مؤكدة بذلك حقيقة قرآنية بأن الإنسان خلق من طين.
وقال فريق بمعهد هاوارد هيوز الطبي ومستشفى ماساتشوستس العام في بوسطن إنه تبين لهم أن أحد المعادن المكونة للطفل أو الطين الصلصالي ويطلق عليه "سليكات الألومنيوم المائية" يساعد الخلايا على استخدام مواد وراثية تسمى الحمض الريبي النووي (RNA) التي تشكل بدورها أحد العناصر الرئيسية للحياة.
وإضافة إلى ذلك فإن الطين الصلصالي يساعد على تكوين أكياس صغيرة من الدهون والسوائل في الخلية الحية.
واستند الباحثون جاك شوستاك ومارتن هانزيتش وشيلي فوجيكاوا إلى بحث سابق خلص إلى أن الطين قد يحفز التفاعل الكيميائي المطلوب لتكوين الحمض الريبي النووي من وحدات بنائية تعرف باسم "النويدات".
وتوصل الباحثون إلى أن الطين سرع من عملية تكوين الأحماض الأمينية لتكوينات تشبه الأكياس الصغيرة تسمى "الحويصلات". كما ينقل الطين أيضا الحمض الريبي النووي إلى داخل هذه الحويصلات.
تسجيل
القائمة المفتوحة
صحة
|
الولايات المتحدة الأميركية
دراسات تؤكد خلق الإنسان من طين
Normal Red Blood Cells
Published On 24/10/2003
24/10/2003
انقر هنا للمشاركة على وسائل التواصل الاجتماعي
شارِكْ
undefined
أثبتت دراسات وبحوث جديدة أن مواد موجودة في الطين لها دور رئيسي في بعض العمليات الأولية لتكوين الحياة مؤكدة بذلك حقيقة قرآنية بأن الإنسان خلق من طين.
وقال فريق بمعهد هاوارد هيوز الطبي ومستشفى ماساتشوستس العام في بوسطن إنه تبين لهم أن أحد المعادن المكونة للطفل أو الطين الصلصالي ويطلق عليه "سليكات الألومنيوم المائية" يساعد الخلايا على استخدام مواد وراثية تسمى الحمض الريبي النووي (RNA) التي تشكل بدورها أحد العناصر الرئيسية للحياة.
وإضافة إلى ذلك فإن الطين الصلصالي يساعد على تكوين أكياس صغيرة من الدهون والسوائل في الخلية الحية.
واستند الباحثون جاك شوستاك ومارتن هانزيتش وشيلي فوجيكاوا إلى بحث سابق خلص إلى أن الطين قد يحفز التفاعل الكيميائي المطلوب لتكوين الحمض الريبي النووي من وحدات بنائية تعرف باسم "النويدات".
وتوصل الباحثون إلى أن الطين سرع من عملية تكوين الأحماض الأمينية لتكوينات تشبه الأكياس الصغيرة تسمى "الحويصلات". كما ينقل الطين أيضا الحمض الريبي النووي إلى داخل هذه الحويصلات.
Hassan Abid
-Clay Has Been Used for Pottery for Over 29,000 Years
-Ancient Civilizations Used Clay for Writing and Records
-Clay Can Naturally Filter Water, Removing Impurities
-Ancient Civilizations Used Clay for Writing and Records
-Clay Can Naturally Filter Water, Removing Impurities
زهراء طالب
ألوان التّربة متعدّدة و تختلف بحسب المادة الأصل الّتي تكوّّنها والمعادن الّتي تحتويها والّلون الغامق للتّربة يسرّع نموّ البذور بسبب شدّة إمتصاصه للإشعاع الشّمسيّ .
Amir Sadeq
Some people seem to believe that religion and science are not compatible with each other. In fact, it is on the contrary! The Quran contains things that can can only be described as miracles, such as how did an Arab almost 1500 years ago know about the big bang, or how planets and stars move in space, or how the fetus develops in it’s mother’s womb?
Clay is the simplest of possible substances. However, it contains the same atoms in a human, made of organs, tissues, cells, and DNA.
There are 94 naturally-occurring elements on earth. They are the building blocks of everything from toys, to cars, to you!
What a miracle! Everything in the universe is made of less than 100 building blocks!
What is even more amazing is that up to 99% of sand is made of silicates, a mix of only 2 elements: Silicon and Oxygen. It is a truly miraculous substance, yet so simple: it makes up rocks, beaches, and gemstones, and can be used to make glass, clay, which you are made from, and concrete. These are lifesavers we could not live without, all from sand, so simple, yet so useful.
Clay is the simplest of possible substances. However, it contains the same atoms in a human, made of organs, tissues, cells, and DNA.
There are 94 naturally-occurring elements on earth. They are the building blocks of everything from toys, to cars, to you!
What a miracle! Everything in the universe is made of less than 100 building blocks!
What is even more amazing is that up to 99% of sand is made of silicates, a mix of only 2 elements: Silicon and Oxygen. It is a truly miraculous substance, yet so simple: it makes up rocks, beaches, and gemstones, and can be used to make glass, clay, which you are made from, and concrete. These are lifesavers we could not live without, all from sand, so simple, yet so useful.
batoul kaddouri
L’argile est une roche aux propriétés remarquables : peu perméable, elle retarde ou limite naturellement leur dispersion dans le milieu géologique.Les roches sont composées de minéraux, substances solides caractérisées par un agencement particulier d'éléments chimiques. Ceux de l’argile appartiennent à la famille des silicates, constitués d’atomes de silicium et d’oxygène mais également d'aluminium, de fer, de calcium ou encore de potassium. Dieu nous a fait d'argile , qui est riche en minéraux qui sont utile pour le corps
Hizber Abidi
Clays can be classified into several categories based on their mineral composition, properties, and uses. Among the most common types are earthenware, stoneware, and porcelain, each with unique characteristics that make them suitable for specific applications
محمد حسن عبد الأمير
الطين مادة طبيعية موجودة في الأرض، تتكون من جزيئات معدنية دقيقة. عند مزجه بالماء، يصبح الطين ليناً وقابلاً للتشكيل؛ وتُعرف هذه الخاصية باللدونة. بعد تشكيله، يمكن تجفيف الطين أو تسخينه ليصبح أكثر صلابة ومتانة
Hoorain Rizvi
Clay and the human body share similarities in being composed of Earth's elements, possessing malleability (though the body resists more), interacting with water and organic matter, and clay potentially aiding early cell formation and the body using clay minerals in medicine and bone health.
Researchers at the Howard Hughes Medical Institute and Massachusetts General Hospital showed that the presence of clay aids naturally occurring reactions that result in the formation of fatty sacks called vesicles, similar to what scientists expect the first living cells to have looked like.
Further, the clay helps RNA form. The RNA can stick to the clay and move with it into the vesicles. This provides a method for RNA’s critical genetic information to move inside a primitive cell.
Hence,It highlights God's omnipotent power to create a complex, living being from inanimate earth.
Researchers at the Howard Hughes Medical Institute and Massachusetts General Hospital showed that the presence of clay aids naturally occurring reactions that result in the formation of fatty sacks called vesicles, similar to what scientists expect the first living cells to have looked like.
Further, the clay helps RNA form. The RNA can stick to the clay and move with it into the vesicles. This provides a method for RNA’s critical genetic information to move inside a primitive cell.
Hence,It highlights God's omnipotent power to create a complex, living being from inanimate earth.
Zahra Kafi
Monkeys, peccaries (a kind of a pig ) and other fauna, eat clay to obtain the trace minerals needed to remain healthy.
Maarif Akbar
The Quran says that Allah created people from clay, which comes from the earth. He made humans step by step and then gave them life, hearing, sight, and hearts to think and feel. Allah created everything in a beautiful way, so we should always be thankful to Him.
زينب عبد الأمير
الطين صخر رسوبي دقيق الحبيبات (صغير الحجم). حجم حبيباته دقيق للغاية لدرجة أن جزيئات المعادن الفردية نادراً ما تُرى بالعين المجردة. تشمل المعادن الشائعة الموجودة في الطين الكاولينيت، والتلك، والبيروفيلليت، وجميع أنواع الميكا، ومعادن مجموعة الكلوريت، والفلسبارات، وكميات أقل من التكتوسيليكات (بما في ذلك الكوارتز)
Fatima Alkheichen
Clay is a natural material made up of tiny particles of rock. When clay is mixed with enough water, it feels like soft, gluey mud.
لجين الاشيقر
Calcium montmorillonite (CMM) clay is a naturally occurring mineral with a longstanding history in medical applications, now receiving increased scientific attention for its broad therapeutic potential. Known for its ability to bind a range of harmful substances, including bacterial toxins, heavy metals, mycotoxins, and inflammatory mediators, it exerts its effects without systemic absorption, acting locally within the gastrointestinal tract or at the skin surface. This narrative review synthesizes current clinical and preclinical evidence on the human health applications of calcium montmorillonite, with focused sections on the gastrointestinal/metabolic, dermatologic, immune, and musculoskeletal systems. The gastrointestinal section covers its documented role in treating pediatric diarrhea, radiation enteritis, and dietary toxin exposure. In dermatology, the clay has been incorporated into topical preparations for acne, rashes, and wound care, supported by both laboratory data and real-world use. Hepatic and metabolic studies suggest that it may reduce liver fat accumulation, improve glucose metabolism, and modulate the gut microbiome, particularly in models of non-alcoholic fatty liver disease and obesity. Additional sections explore its potential relevance in renal toxin clearance, immune regulation, mucosal healing, and surgical recovery. Across these systems, calcium montmorillonite has demonstrated a strong safety profile, with minimal nutrient interaction and no evidence of systemic toxicity when properly sourced and used in appropriate contexts. With growing access to carefully studied, pharmaceutical-grade formulations, CMM may offer safe and consistent benefits across clinical and preventive care settings.
مهدي الاشيقر
فقد روى في الوسائل عن الامام الثاني عشر
الحجه عليه السلام ان الحميري كتب اليه يسئله عن السجده على لوح من طين قبر الحسين هل فيه فضل ؟فاجاب عليه السلام يجوز لك وفيه الفضل ثم سأله عن السبحه فأجاب بمثل ذلك فيظهر ان صنع التربه أقراصا وألواحا كما هو المتعارف اليوم كان متعارفا من ذلك العصر اي وسط القرن الثالث حدود المائتين وخمسين هجريه وفيها قال روي عن الصادق ان السجود على طين قبر الحسين ينور الأرضين السبع ومن كانت معه سبحه من قبر الحسين كتب مسبحا
الحجه عليه السلام ان الحميري كتب اليه يسئله عن السجده على لوح من طين قبر الحسين هل فيه فضل ؟فاجاب عليه السلام يجوز لك وفيه الفضل ثم سأله عن السبحه فأجاب بمثل ذلك فيظهر ان صنع التربه أقراصا وألواحا كما هو المتعارف اليوم كان متعارفا من ذلك العصر اي وسط القرن الثالث حدود المائتين وخمسين هجريه وفيها قال روي عن الصادق ان السجود على طين قبر الحسين ينور الأرضين السبع ومن كانت معه سبحه من قبر الحسين كتب مسبحا
Ahmad Moana
dans certaines conditions, un sol argileux peut passer d’une consistance ferme à une consistance presque liquide sans ajout d’eau externe, simplement à cause de la perturbation de sa structure interne.